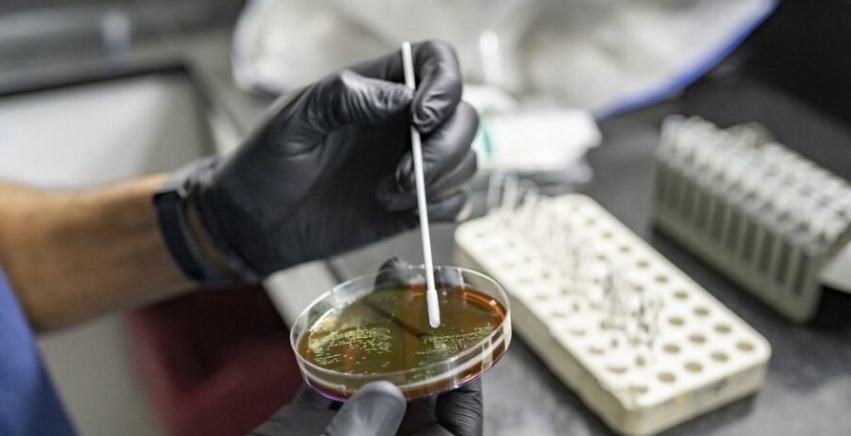
...

La crisis de resistencia a los antimicrobianos “es ya un hecho”, dice el responsable de la OMS
Una científica venezolana investiga la resistencia a los antimicrobianos (RAM), considerada una de las 10 principales amenazas para la salud pública mundial, que se produce cuando los virus cambian con el tiempo y dejan de responder a los medicamentos.
El director general de la Organización Mundial de la Salud (OMS) declaró el pasado viernes 15, durante la Cuarta reunión ministerial mundial sobre resistencia a los antimicrobianos que ésta no sólo “amenaza” con hacer menos eficaces los medicamentos de los que dependemos, sino que “ya está ocurriendo”.
Desde Jeddah, Arabia Saudí, Tedros Adhanom Ghebreyesus afirmó que lo que se está debatiendo no es sólo el riesgo de que la gente muera a causa de infecciones por super bacterias, sino que ya “están muriendo 1,3 millones de personas cada año”. Prosiguió afirmando que tomar medidas “es tan urgente como la acción por el clima”.
El doctor Tedros se refirió a la Declaración Política relacionada a esta materia acordada el pasado mes de septiembre por la Asamblea General de la ONU, la cual establece objetivos claros. “La tarea ahora es traducirla en acciones concretas”, indicó.
El responsable de la agencia sanitaria destacó tres prioridades para la aplicación de dicha Declaración, en particular para los países de ingresos bajos y medios:
aumentar la financiación sostenible procedente de fuentes nacionales e internacionales
aumentar la investigación, el desarrollo y la innovación
aumentar el acceso equitativo a antimicrobianos de calidad, garantizando al mismo tiempo un uso adecuado
“La ironía de la resistencia es que está impulsada por el uso inadecuado de antimicrobianos, y sin embargo un gran número de personas también mueren porque no pueden acceder a estos medicamentos en absoluto”, dijo.
Haciendo hincapié en que la resistencia antimicrobiana “está aquí y ahora, pero también lo están las soluciones”, el doctor Tedros hizo un llamamiento para que aprovechen la oportunidad que se presenta en la Conferencia de Jeddah “y acelerar la acción, comprometerse a una colaboración más estrecha y proteger los medicamentos que nos protegen”.
La resistencia se produce cuando bacterias, virus, hongos y parásitos dejan de reaccionar a los fármacos antimicrobianos. La farmacorresistencia hace ineficaces los antibióticos y otros tratamientos antimicrobianos y dificulta o imposibilita el tratamiento de las infecciones.
Esto puede dar lugar a super bacterias que no pueden ser detenidas por los medicamentos, que son la primera opción para tratar las enfermedades que estos gérmenes causan, aumentando el riesgo de transmisión de enfermedades graves, discapacidad y muerte.
Te puede interesar

Descarrila tren de carga en Aguascalientes; muere un migrante y siete resultan lesionados
Por redacción
20 mar., 2026Leer más

Veracruz ofrece recompensa por tercera vez para capturar a “El Bukanas”
El presunto líder dedicado al robo de hidrocarburo volvió a escapar en Chignahuapan; autoridades aseguraron armas y explosivos. La Fiscalía de Veracruz ofrece 350 mil pesos por información que lleve a su captura.
20 feb., 2026Leer más

Marino arriesga su vida para salvar a dos adolescentes en Baja California
Por redacción
06 abr., 2026Leer más

Tragedia en la Toluca-Valle de Bravo: Fallece hijo del Director General de BBVA en choque frontal
Trágico accidente automovilístico registrado la tarde del pasado viernes cobró la vida de tres personas, entre ellas el joven Diego Osuna Miranda, de 17 años, hijo de Eduardo Osuna, vicepresidente y director general de BBVA México.
15 mar., 2026Leer más

Ataque de pitbulls deja siete alumnos heridos en escuela de Minatitlán
Por redacción
27 ene., 2026Leer más

Bloqueo de transportistas hoy: Gobierno reporta 11 cierres en 9 estados del país
Por redacción
06 abr., 2026Leer más
